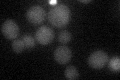

View description
Subunit IV of cytochrome c oxidase, the terminal member of the mitochondrial inner membrane electron transport chain; precursor N-terminal 25 residues are cleaved during mitochondrial import; phosphorylated; spermidine enhances translation
Localization:
Intensity:
Fold change:
Significance:
-
C’ GFP library in SD
below threshold16.76 -
N' NOP1pr-GFP in SD

mitochondria162.694 -
N' TEF2pr-mCherry in SD

mitochondria278.107 -
N' NATIVEpr-GFP in SD

mitochondria67.2827 -
N' TEF2pr-VC and Cyto-VN in SD

#N/A0 -
C’ GFP library in SD+DTT

cytosol14.920.89No -
C’ GFP library in SD+H2O2

cytosol15.690.93No -
C’ GFP library in Starvation Media

cytosol14.780.88No -
C’ GFP library on the background of Pup2-DaMP

below threshold -
C’ GFP library on the background of CCT mutant

below threshold15.48550.923398No
